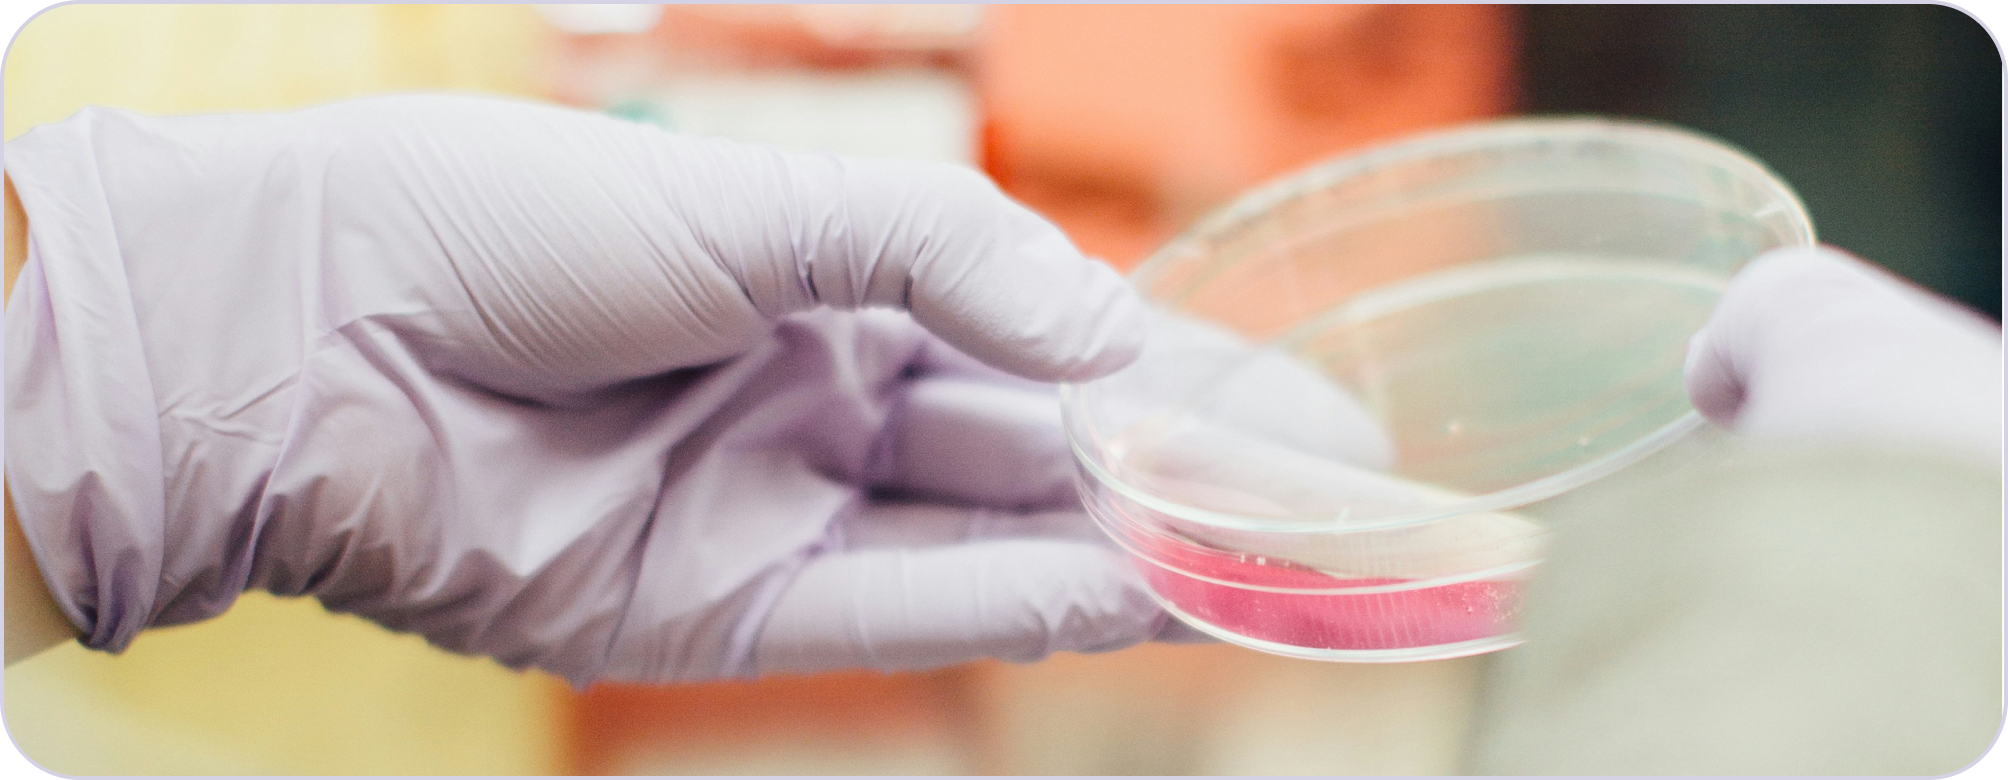

At Pulsetto, we’re committed to helping you save on your purchases with exclusive discounts. Browse through our range of special offers and enjoy savings on your future orders. Free delivery is applied to all orders when you purchase a Pulsetto Vagus Nerve Stimulator.
Note: Discount codes cannot be combined.